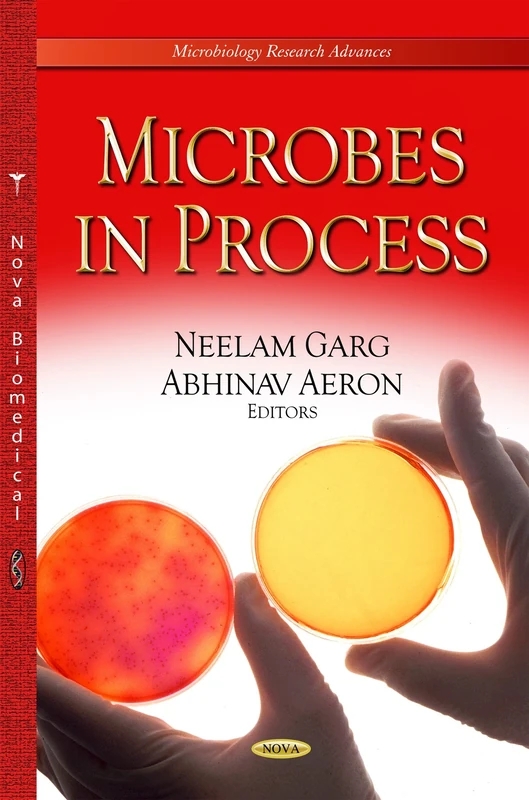
MICROBES IN PROCESS (Microbiology Research Advances)

We can't find the internet
Attempting to reconnect
Something went wrong!
Hang in there while we get back on track

£152.99
Microbial Catalysts: Volume 1
Price data last checked 133 day(s) ago - refreshing...
We'll watch every seller, every day. One email when your price arrives.
Same price for 23 weeks. Today is much like next week.
£153 for 162 days straight · last change was Aug 2025
NEW HERE?
Amazon shows you one price. We show you all of them.
Tosheroon watches Amazon prices so you don't have to. Every product on Amazon has a price history — we make it visible. Set the price you'd actually pay, and we'll email you the second it gets there. No app, no account, one email.
WHAT'S ON THIS PAGE
when this has been cheap or pricey
where the price is heading next
all-time high & low, recent range
name your number, we'll email you
Price History & Forecast
Grey patches = out of stock. Cheaper = lower on the chart. Hover for exact prices.
Last 598 days • 598 data points (No recent data available)
Price Distribution
Price distribution over 598 days • 6 price levels
Price Analysis
Most common price: £149 (252 days, 42.1%)
Price range: £145 - £156
Price levels: 6 different prices over 598 days
Description
Product Specifications
- Format
- hardcover
- ASIN
- 153614679X
- Domain
- Amazon UK
- Release Date
- 19 April 2019
- Listed Since
- 06 November 2018
Barcode
No barcode data available
Similar Products You Might Like
MICROBES IN PROCESS (Microbiology Research Advances)

Industrial Microbiology: Microbes in Action (Microbiology Research Advances)

Plant Biotechnology, Volume 1: Principles, Techniques, and Applications
CRC Press

Proceedings of the Second International Conference on the Future of ASEAN (ICoFA) 2017 - Volume 1: Business and Social Sciences
Springer

Drugs, Stress and Human Function
Cognella Academic Publishing

Microbial Biotechnology: Technological Challenges and Developmental Trends
CRC Press

Communication and Intelligent Systems: Proceedings of ICCIS 2019: 120 (Lecture Notes in Networks and Systems, 120)
Springer

Antimicrobials: Synthetic and Natural Compounds
CRC Press

Space Security Law
Springer

Microbial Diversity in Ecosystem Sustainability and Biotechnological Applications: Volume 2. Soil & Agroecosystems
Springer

Microalgae in Waste Water Remediation
CRC Press

Recent Studies on Computational Intelligence: Doctoral Symposium on Computational Intelligence (DoSCI 2020): 921
Springer

Healthcare Strategies and Planning for Social Inclusion and Development: Volume 1: Health for All - Challenges and Opportunities in Healthcare Management
Academic Press

Advanced Digital Image Processing and Its Applications in Big Data
CRC Press

Knowledge-Intensive Economies and Opportunities for Social, Organizational, and Technological Growth (Advances in Knowledge Acquisition, Transfer, and Management)
Information Science Reference

Springer - Broadening Cultural Horizons in Social Marketing
Springer

Information Science Reference - Knowledge-Intensive Economies
Information Science Reference

Pakistan at Seventy: A handbook on developments in economics, politics and society (Europa Perspectives: Emerging Economies)
Routledge

Biofertilizers: Volume 1: Advances in Bio-inoculants (Woodhead Publishing Series in Food Science, Technology and Nutrition)
Woodhead Publishing

Human Microbiome in Health and Disease - Part A (Volume 191) (Progress in Molecular Biology and Translational Science, Volume 191)
Academic Press

Computational Intelligence and Its Applications in Healthcare
Academic Press

Microbial Syntrophy-mediated Eco-enterprising (Developments in Applied Microbiology and Biotechnology)
Academic Press

Recent Advancements in Bioremediation of Metal Contaminants (Advances in Environmental Engineering and Green Technologies)
Engineering Science Reference

Sustainable Environmental Clean-up: Green Remediation
Elsevier